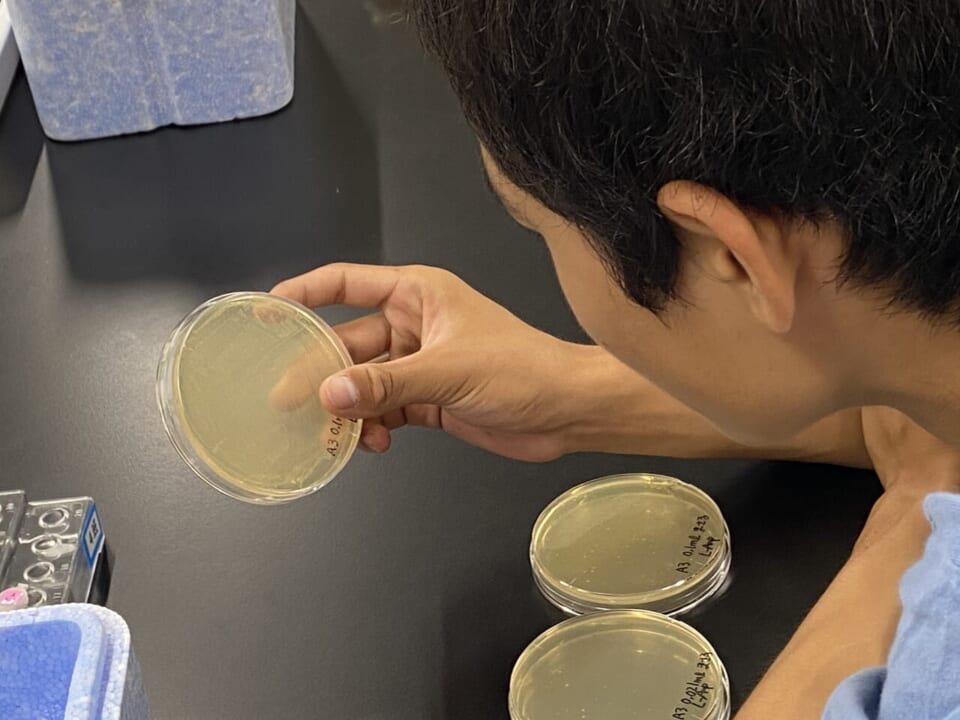
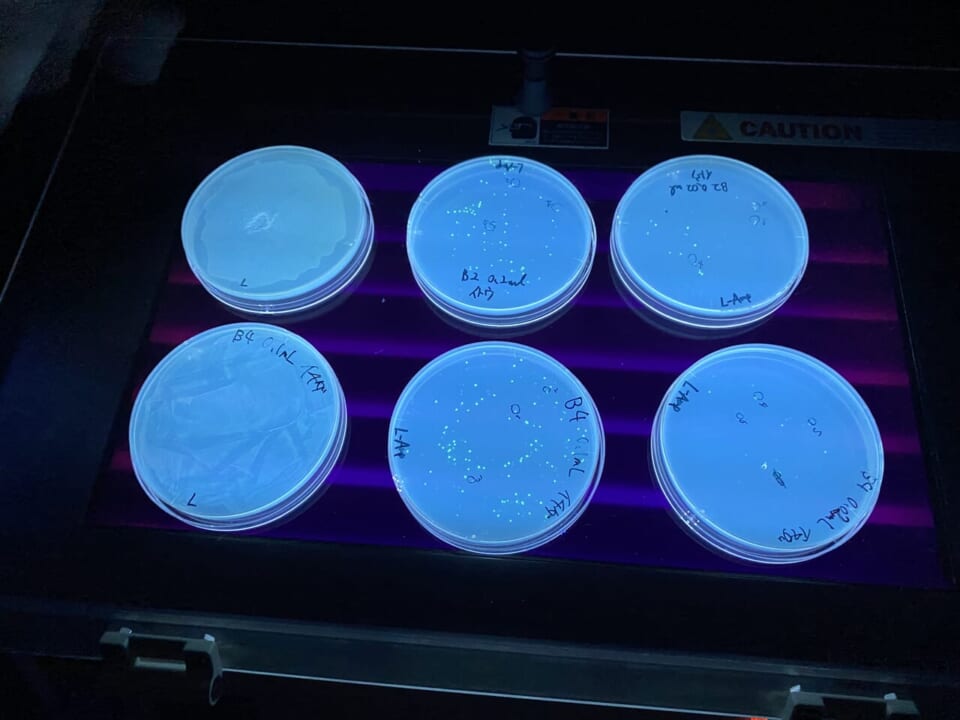

9月20日〜21日に「高校生のためのバイオサイエンスキャンプ in 長浜」を開催!長浜バイオ大学にて研究体験3種を実施!

2025年9月20日(土)・21日(日)の2日間に渡って「高校生のためのバイオサイエンスキャンプ in 長浜 〜大学での研究体験を仲間と楽しもう!〜」(主催:長浜市)を開催しました。全国から集まった25名の高校生が参加しました。
本プログラムは、長浜市による「学びの実験室NEXT産官学連携プロジェクト委託業務」の一環として実施しました。本事業ではバイオテクノロジーを活かして多様な社会課題の解決に取り組む地域産業人材の育成を目指し、プログラムを通じて高校生らが自身の興味・関心とバイオテクノロジー分野との接点を見出す機会を提供しました。
今回は長浜バイオ大学の協力を得て、会場として大学の実習室や研究機器等を利用させていただいた他、大学研究者と研究体験プログラムを開発して実施しました。また、同大学の大学生・大学院生にティーチングアシスタントとして当日の体験サポートや高校生との交流企画に参加していただきました。
<開催概要>
日 程:2025年9月20日(土)10:00 ~ 21日(日)17:00
場 所:JR長浜駅 改札を出て左にある市内マップ掲示の前
参 加 者:高校1年生〜3年生、27名
形 式:1泊2日の宿泊
宿 泊:県民共済ドーム長浜宿泊研修館(滋賀県長浜市田村町1411−1)
参 加 費:無料
備 考:集合場所(JR長浜駅)への旅費・交通費は参加者負担
長浜市の食文化を学ぶウェルカムランチ
長浜駅に集合した参加者らは、北ビワコホテルグラツィエへ移動し、長浜市 未来創造部 部長 和田本啓 氏の歓迎の挨拶や、リバネスによるプログラムの説明を受けたあと、2日間ともに時間を過ごす仲間たちとウェルカムランチを堪能しました。ランチメニューの中には長浜名物の「焼鯖そうめん」もあり、その由来や歴史について学びながら食事を楽しみました。
![]() |
![]() |
![]() |
![]() |
実施した3種の研究体験
ランチのあとは長浜バイオ大学へ移動し、協力教員のサポートのもと、3つの研究体験がスタートしました。長浜市の自然や大学ならではの研究機器に触れながら、2日間に渡って研究体験を行いました。
①水生生物のオリジナル図鑑をつくろう!
協力教員:
大学周辺に流れる河川をフィールドに、生息する水生生物の採集と分類・調査を行います。滋賀県・長浜市の水環境にどのような生物が生息しているのか調査しました。また、制限酵素を用いたPCR-RFLP法によるメダカの系統解析にも挑戦しました。
![]() |
![]() |
![]() |
![]() |
![]() |
![]() |
②電子顕微鏡で植物を観察・分類しよう!
大学近隣にある田村山にて、植物や昆虫を採集し、図鑑等を用いて分類・同定を行いました。また、採集した生物について電子顕微鏡での観察を行い、ミクロの視点で生物観察を行いました。
![]() |
![]() |
![]() |
![]() |
![]() |
![]() |
③遺伝子組み換えで光る大腸菌をつくろう!
大学の実験室で、遺伝子組み換え技術を体験しました。大腸菌にヒートショック法をもちいて形質転換を行い、緑色蛍光タンパク質(GFP)の遺伝子を含むプラスミドDNAを大腸菌へ導入し、光る大腸菌を作成しました。
![]() |
![]() |
![]() |
![]() |
![]() |
![]() |
長浜バイオ大学の大学生・大学院生と交流!
1日目の最後には、研究体験をサポートする大学生・大学院生の先輩方との交流を行いました。いくつかのグループにわかれ、現在取り組んでいる研究や、大学・研究室を選択した経緯、普段の大学生活などについて話を聞くことができました。熱心に研究に取り組む先輩たちの話を聞いてもらい、大学での研究活動への興味喚起を行いました。
![]() |
![]() |
研究体験の成果をプレゼンテーション!
プログラムの最後に、2日間に渡って体験したことの成果を各チームから発表していただきました。地元で採集したときとは違ってカネヒラ(タナゴの仲間)が採集できた喜びや、電子顕微鏡による観察で虫こぶの中にいたタマバチの幼虫を発見できた驚き、学校ではやったことのない実験操作への関心など、実験や調査の結果だけでなく、体験しての感想を聞くことができました。
![]() |
![]() |
![]() |
![]() |
参加者の感想
- 今回のプログラムに参加して、環境保全を目指した研究にはたくさんのフィールドワークをしたり、様々な分野から見ることが必要だと思ったので、寄り道上等で学んでいきたいです。
- 大学は部屋にこもって難しい作業をたくさんする研究ばかりかと思っていましたが、実際に川へ行ってフィールドワークをして、そこからも観察やメダカの種類を突き止める研究で、想像以上に活動的で楽しい研究で驚きました。
- 県外のこのプログラムがなかったら出会えないような人たちと出会えたのがうれしかった。個性的な人ばかりでそれぞれが興味があることに本気で自分も好きなことを極めていきたいと思った。
- 今プログラムを通してバイオ分野というのは多々ある研究分野の中で裾野が広いものだと感じました。
- 研究するということを少ししれたような気がしました。研究者ってすごいと思いました。
- 自分は長浜バイオ大学ほどバイオに特化した大学を見た事がなかったので驚きました。大学内にたくさんの研究室があるのはもちろん、研究を手厚くサポートできるような教授が多くいるので気になることを追求できるような大学だと感じました。
- 研究に関しての手厚いサポートや大学内のリアルな話、行っている研究の面白い話を話して下さりありがとうございます!とても面白く聞けました。
その他、当日の様子
![]() |
![]() |
![]() |
![]() |
![]() |
![]() |
![]() |
![]() |
![]() |
![]() |
![]() |
![]() |
![]() |
![]() |
<本件に関するお問い合わせ>
株式会社リバネス 教育開発事業部
担当:仲栄真
TEL:06-6125-5622
MAIL:[email protected]